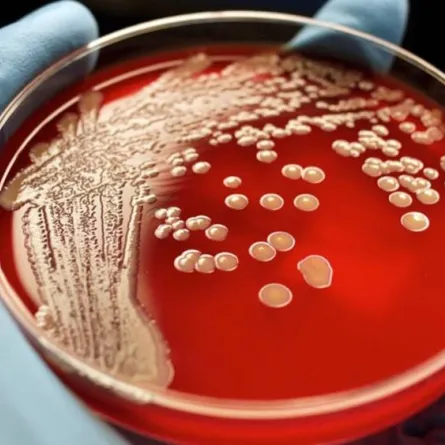
اكتشاف أكبر بكتيريا في العالم تُرى بالعين المجردة

لعبت الحيوانات البرّية دوراً مهماً في الحفاظ على التوازن البيئي وتلبية حاجات الإنسان المعيشية، وتتسم هذه الحيوانات بالقوة والعنف، وتعيش بشريعة الغابة وعلى قاعدة البقاء للأقوى، فقد يكون بعضها فريسة سهلة للحيوانات اللاحمة، وبعضها الآخر يمكن أن يفلت إذا كان أسرع من المفترس الذي يهاجمه. يقول الدكتور محمد رمضان أستاذ الأحياء لسيدتي: الحيوانات البرّية قادرة على التعايش والتأقلم مع مختلف متغيرات الحياة البيئية والانسجام معها، وهي تعتمد على نفسها في تأمين مأوى لها، وفي تأمين غذائها من الحيوانات الأخرى أو النباتات.
إليكم أسرع حيوانات بريّة في العالم

-الفهد الصّياد (الشيتا):
تصل سرعة حيوان الفهد (الشيتا) إلى 120 كم في الساعة!! ويستطيع أن يصل من سرعة 0 إلى سرعة 110 كم في الساعة خلال 3 ثوانٍ فقط، أي بمعدل تسارع أكبر من أي سيارة حديثة تم اختراعها حتى الآن!!!، ولا يستطيع الجري بهذه السرعة لفترة كبيرة لأنه ليس من ذوي النفس الطويل بل يستخدمها فقط للصيد في اللحظة المناسبة التي يستطيع أن ينقض على فريسته ويضع مخالبه عليها.
- الظبي:
وتبلغ سرعته 104 كم وهو حيوان ثديي من ذوات الأظلاف، والعضو الوحيد الباقي على قيد الحياة من عائلة Antilocapridae يعرف أيضاً باسم الوعل الشائك أو الشائك القرن أو الظبي الأميركي، يتراوح ارتفاع كتفه عن الأرض بين 80 و100 سنتيمتر وهو بلون بني ضارب إلى الحمرة وله عُرف قصير بني اللون، وهو أبيض اللون من الجهة السفلى وله شريطان أبيضان على الحلق وبقعة بيضاء اللون كبيرة الحجم على الردف وعند الشعور بالخطر ينتصب الشعر الموجود على الردف كعلامة تحذير. وبإمكان المرء مشاهدته من مسافة 3 أو 4 كيلومترات، وللذكر والأنثى قرنان يتفرع منهما فرعان ناتئان، الطويل يتجه إلى الخلف والقصير يشير إلى الأمام.
يحيا هذا الظبي منفرداً أو ضمن جماعات في الصيف، أما في الشتاء فإنه يؤلف قطعاناً كبيرة، يجتمع الذكر بالإناث في أواخر الصيف وبعد ثمانية أشهر تلد الأنثى صغيراً واحداً أو صغيرين. وقد كان هذا الظبي يعيش في المناطق الممتدة من البرتا حتى شمال المكسيك لكن أعداده الآن تتناقص، كما تحدد مجال انتشاره أيضاً وبعض أجناسه معرضة لخطر الانقراض
- حيوان النو:
وتبلغ سرعته حوالي 85 كم ويعرف أيضا بالثَّيْتَلِ الأفريقي.هو نوع من الظباء القاطنة للأراضي العشبيّة والذي يتواجد عبر معظم أفريقيا الغربية، أفريقيا الشرقية، والجنوبية، ويعتبر الثيتل أحد ثلاثة أنواع من الظباء التي تنتمي إلى جنس الثياتل الحقيقية.”
يبلغ ارتفاع الثيتل 1.5 متر عند الكتفين (5 أقدام) ويزن ما بين 120 و 200 كيلوغرام (265-440 رطلاً)، ويكون لون ذكور هذه الحيوانات بنيّاً قاتماً، بينما تكون الإناث بنيّة ضاربة إلى الصفار، ولديه قرون يصل طولها إلى 70 سنتيمتراً (27 إنشاًً).
- الأسد:
وتبلغ سرعته حوالي 85 كم، والأسد حيوان من فصيلة السنوريات الكبيرة المنتمية لجنس النمر، يفوق وزن الذكور الكبيرة منه 250 كيلوغراماً (550 رطلاً). تعيش معظم الأسود البرية المتبقية اليوم في أفريقيا جنوب الصحراء الكبرى، كان موطن الأسود شاسعاً جداً في السابق، حيث كانت تتواجد في شمال أفريقيا، الشرق الأوسط، وآسيا الغربية، حيث انقرضت منذ بضعة قرون فقط. ويختلف أمد حياة الأسود باختلاف جنسها، فاللبوات التي تعيش في مناطق محميّة آمنة مثل متنزه كروغر الوطني قد تصل لما بين 12 و14 عاماً، بحال تخطّت مخاطر ومشقات حياة الأشبال، بينما لا تتخطى الذكور 8 سنوات من حياتها إلا فيما ندر.
*البراري غير المفترسة

- الغزال ذو القرون:
وتبلغ سرعته حوالي 85 كم ويقال إنه يمتلك رئتين كبيرتين وقلباً يساعده على ضخ الدم وتوصيل الأوكسجين للعضلات بشكلٍ سريع، كما يمتلك حاسة بصر قوية، وهو يعيش في النصف الشمالي من العالم.
- الحصان الربعي:
سُميّ هذا الحيوان بالحصان الربعي نظراً لقدرته على السباق بمسافة ربع الميل، وتبلغ سرعته حوالي 80 كم فهو يتميز بقدرة على الإقلاع السريع في السباقات وله ميزة رائعة، وهي أن رجليه الأماميتين قويتان جداً، ولكنه قصير بعض الشيء ويستخدم في المزارع لقوته الكبيرة وسهولة ترويضه
- حيوان الأيل:
وتبلغ سرعته 76 كم وتعتبر الأيليات آخر الحيوانات البرية المجترة في المناطق المعتدلة. وتوجد منها عبر العالم 44 نوعاً تتوزع على 17 جنساً، الأكثر انتشاراً في غابات أوروبا هي الأيل الأحمر (Cervus elaphus)، والأيل الأسمر الأوروبي. وفي إسكندينافيا نجد الرنة الذي يوجد أيضا بأوروبا الوسطى. كما نجد أيل سيكا (Cervus nippon)
- الكلاب البرية الأفريقية المنقطة:
وتبلغ سرعتها حوالي 76 كم، ويشبه الكلب الكبير ولكنه منقط، وله آذان كبيرة مستديرة لا تخطئها العين، ورأسه يشبه رأس الضبع، أسود من الأمام، والجبهة بها خط أسود رأسي يمتد إلى ما بين الأذنين. الأرجل طويلة أسطوانية وقوية، تنتهي بأربعة أصابع فقط، ولون الجسم بني تكسوه نقاط لونها أسود، ولكن الذيل ينتهي دائماً بخصلة بيضاء من الشعر الخشن. وينتشر في المناطق شبه الصحراوية من قارة أفريقيا حيث السافانا ولم يُعرف أنه يسكن الغابات. ويعيش هذا النوع من الكلاب في مجموعات قد تصل إلى 50 فرداً، وفترة الحمل في هذا النوع تصل إلى 72 يوماً.
- ذئب البراري القَيّوط أو الوعوع:
وتبلغ سرعته حوالي 73، ويعيش في السهول المفتوحة في شمال أمريكا من كوستاريكا إلى آلاسكا. يبلغ طوله 90 سم ويقال إنه يصل إلى 135سم طولاً. وطول ذيله من (30-40سم) وكتلته (9-12كغم)، يجري القيوط بسرعة تصل إلى 64كيلومتر/ساعة. وتحمل الأنثى ما بين (5-10جراء) ولمدة (60-65يوماً) وذئب القيوط لا يخرج للصيد في جماعة إنما يكون منفرداً أو في أزواج من نوعه، أما إذا رئي في جماعة فلكي يقوم الآباء والأمهات بتعليم صغارها فن الصيد.
- الثعلب الرمادي:
لا يمكنك تصديق أن هذا النوع من الحيوانات وبهذا الحجم يمكن تصنيفه ضمن أسرع الحيوانات في العالم، حيث تبلغ سرعته القصوى سرعته 71 كم في الساعة.












 Google News
Google News